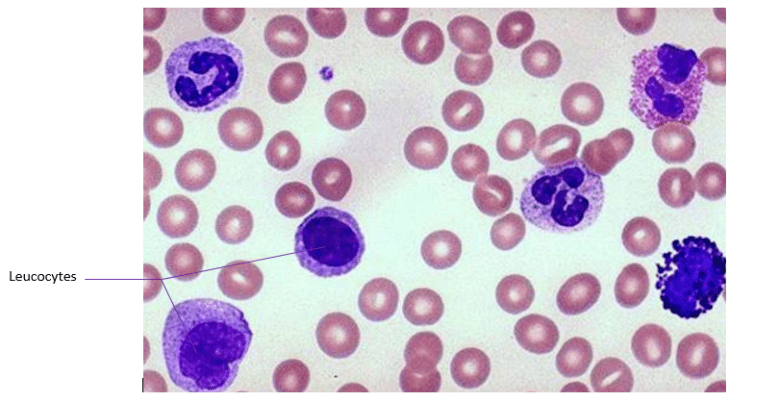
leucocytes

Le sommeil lent semble être la principale période de restauration du corps.
Le système immunitaire est renforcé pendant le sommeil, ce qui accélère la guérison. Le défaut de sommeil entraîne un manque de leucocytes dans le sang (globules blancs, cellules sanguines responsables du système immunitaire). Les personnes en privation de sommeil présentent moins de la moitié des anticorps protecteurs après un vaccin d’inoculation que les personnes ayant des habitudes de sommeil saines.
Goutte de sang observée au microscope
Le sommeil lent profond (phase 3) a été associé à la production de l’hormone de croissance, qui est indispensable à la régénérescence et la réparation des tissus cellulaires et stimule également la prise de masse musculaire. Chez l’enfant, le sommeil est donc primordial pour la croissance.
En outre, la plupart de nos processus homéostatiques (la régulation de l’environnement interne du corps) se produisent automatiquement, et beaucoup d’entre eux ont lieu pendant le sommeil. Le sommeil permet de maintenir un équilibre des hormones, de la pression artérielle, du taux de glycémie, de la température du corps. Le corps a du temps à consacrer à ce genre de travaux de stabilisation et d’entretien, quand les pressions et les stress de la vie quotidienne sont réduits. Ainsi, lors d’une mauvaise régulation de ces fonctions essentielles, c’est-à-dire lors d’un manque de sommeil, les risques de maladie cardiaque, de maladie rénale, d’hypertension artérielle, de diabète, d’obésité et d’AVC sont accrus.
Page suivante : Mémoire et plasticité cérébrale